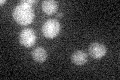
YHR191C
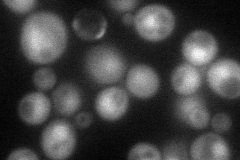
YHR191C
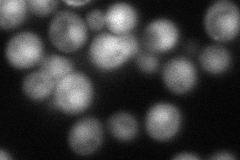
YHR191C
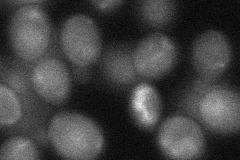
YHR191C

View description
Subunit of a complex with Ctf18p that shares some subunits with Replication Factor C and is required for sister chromatid cohesion
Localization:
Intensity:
Fold change:
Significance:
-
C’ GFP library in SD
below threshold17.86 -
N' NOP1pr-GFP in SD
cytosol,nucleus69.7534 -
N' TEF2pr-mCherry in SD
nucleus58.3495 -
N' NATIVEpr-GFP in SD

nucleus29.3564 -
N' TEF2pr-VC and Cyto-VN in SD
cytosol31.8676 -
C’ GFP library in SD+DTT

cytosol17.560.98No -
C’ GFP library in SD+H2O2

cytosol16.020.89No -
C’ GFP library in Starvation Media

cytosol16.910.94No -
C’ GFP library on the background of Pup2-DaMP

below threshold -
C’ GFP library on the background of CCT mutant

below threshold15.53940.869962No
